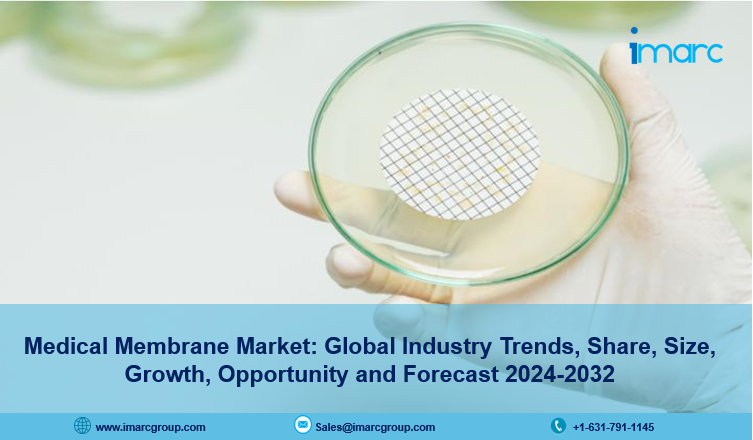

IMARC Group's report titled "Medical Membrane Market Report by Technology (Microfiltration, Ultrafiltration, Nanofiltration, Dialysis, Gas Filtration, and Others), Material (Acrylics, Polypropylene (PP), Polyvinylidene Fluoride (PVDF), Polysulfone (PSU) and Polyether Sulfone (PESU), Polytetrafluoroethylene (PTFE), and Others), Application (Pharmaceutical Filtration, IV Infusion and Sterile Filtration, Bio-Artificial Processes, Drug Delivery, Hemodialysis, and Others), and Region 2024-2032", offers a comprehensive analysis of the industry, which comprises insights on the global medical membrane market forecast. The global market size reached US$ 3.9 Billion in 2023. Looking forward, IMARC Group expects the market to reach US$ 7.7 Billion by 2032, exhibiting a growth rate (CAGR) of 7.5% during 2024-2032.
For an in-depth analysis, you can refer sample copy of the report: https://www.imarcgroup.com/medical-membrane-market/requestsample
Factors Affecting the Growth of the Medical Membrane Industry:
- Increasing Incidences of Chronic Diseases:
The rising prevalence of numerous chronic diseases, like cardiovascular ailments, diabetes, and renal disorders, among the masses across the globe is propelling the market growth. These conditions necessitate treatments, such as hemodialysis and drug delivery systems, where medical membranes play a crucial role. The increasing demand for medical membranes for therapeutic interventions is contributing to the growth of the market. In addition, the rising awareness about the importance of medical membranes in addressing the healthcare needs of individuals affected by chronic conditions is bolstering the market growth.
- Technological Advancements:
Innovations in material science, manufacturing processes, and design are enhancing the performance, reliability, and versatility of medical membranes, which is supporting the market growth. These advancements enable the development of membranes with improved biocompatibility, durability, and selective permeability, expanding their applications in various medical procedures. Moreover, the rising development of next-generation medical devices and therapies is strengthening the market growth. Advancements in manufacturing technologies, such as additive manufacturing three-dimensional (3D) printing and electrospinning, enable the precise fabrication of medical membranes with complex geometries and tailored properties.
- Growing Demand for Dialysis Services:
The escalating demand for medical membranes on account of the rising prevalence of end-stage renal disease (ESRD) and kidney failure among individuals is contributing to the growth of the market. Dialysis membranes play a critical role in hemodialysis, a life-sustaining treatment for individuals with impaired kidney function. In addition, the growing demand for dialysis services due to the increasing access to healthcare services and awareness about kidney diseases is offering a positive market outlook. Besides this, advancements in membrane technology enhances the efficiency and efficacy of dialysis treatments, which are impelling the market growth.
Leading Companies Operating in the Global Medical Membrane Industry:
- 3M Company
- Asahi Kasei Medical Co. Ltd. (Asahi Kasei Corporation)
- Hangzhou Cobetter Filtration Equipment Co. Ltd.
- Koch Separation Solutions (Koch Engineered Solutions)
- Medtronic plc
- Merck KGaA
- Pall Corporation (Danaher Corporation)
- Sartorius AG
- Thermo Fisher Scientific
- W. L. Gore & Associates Inc.
Medical Membrane Market Report Segmentation:
By Technology:
- Microfiltration
- Ultrafiltration
- Nanofiltration
- Dialysis
- Gas Filtration
- Others
Nanofiltration represents the largest segment as it selectively separates molecules based on size and charge.
By Material:
- Acrylics
- Polypropylene (PP)
- Polyvinylidene Fluoride (PVDF)
- Polysulfone (PSU) and Polyether Sulfone (PESU)
- Polytetrafluoroethylene (PTFE)
- Others
Polysulfone (PSU) and polyether sulfone (PESU) hold the biggest market share on account of the rising focus on the safety and efficacy of medical treatments.
By Application:
- Pharmaceutical Filtration
- IV Infusion and Sterile Filtration
- Bio-Artificial Processes
- Drug Delivery
- Hemodialysis
- Others
Pharmaceutical filtration accounts for the largest market share due to stringent quality standards.
Regional Insights:
- North America (United States, Canada)
- Asia Pacific (China, Japan, India, South Korea, Australia, Indonesia, Others)
- Europe (Germany, France, United Kingdom, Italy, Spain, Russia, Others)
- Latin America (Brazil, Mexico, Others)
- Middle East and Africa
Europe enjoys a leading position in the medical membrane market, which can be attributed to the presence of well-established healthcare systems with high levels of access to medical services.
Global Medical Membrane Market Trends:
The growing demand for medical membranes due to the increasing geriatric population worldwide is offering a positive market outlook. Older individuals are more susceptible to chronic diseases, age-related health issues, and organ failure, necessitating medical interventions that rely on membranes for treatments like wound care, tissue engineering, and organ support. The rising awareness about the importance of medical membranes in addressing healthcare needs is impelling the market growth.
Apart from this, stringent regulations related to healthcare product quality and safety are bolstering the market growth. Furthermore, advancements in medical membrane technologies ensure compliance and improve patient outcomes.
Note: If you need specific information that is not currently within the scope of the report, we will provide it to you as a part of the customization.
About Us:
IMARC Group is a leading market research company that offers management strategy and market research worldwide. We partner with clients in all sectors and regions to identify their highest-value opportunities, address their most critical challenges, and transform their businesses.
IMARCs information products include major market, scientific, economic and technological developments for business leaders in pharmaceutical, industrial, and high technology organizations. Market forecasts and industry analysis for biotechnology, advanced materials, pharmaceuticals, food and beverage, travel and tourism, nanotechnology and novel processing methods are at the top of the company’s expertise.
Our offerings include comprehensive market intelligence in the form of research reports, production cost reports, feasibility studies, and consulting services. Our team, which includes experienced researchers and analysts from various industries, is dedicated to providing high-quality data and insights to our clientele, ranging from small and medium businesses to Fortune 1000 corporations.
Contact US:
IMARC Group
134 N 4th St. Brooklyn, NY 11249, USA
Email: [email protected]
Tel No:(D) +91 120 433 0800
United States: +1-631-791-1145 | United Kingdom: +44-753-713-2163

Comments